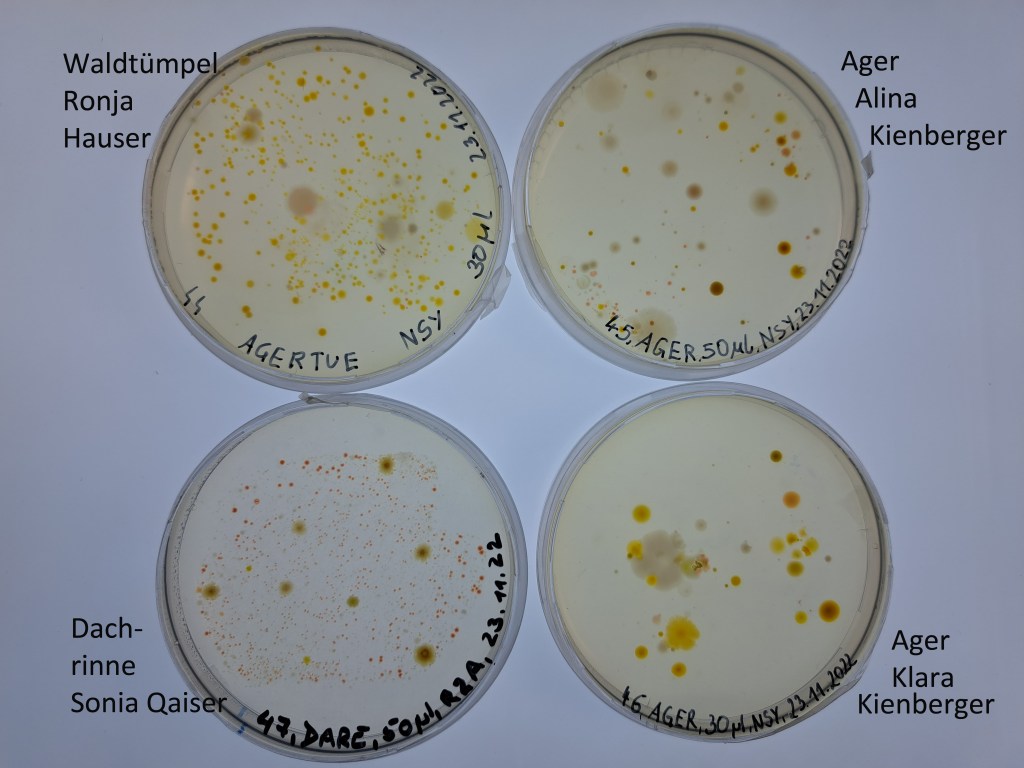
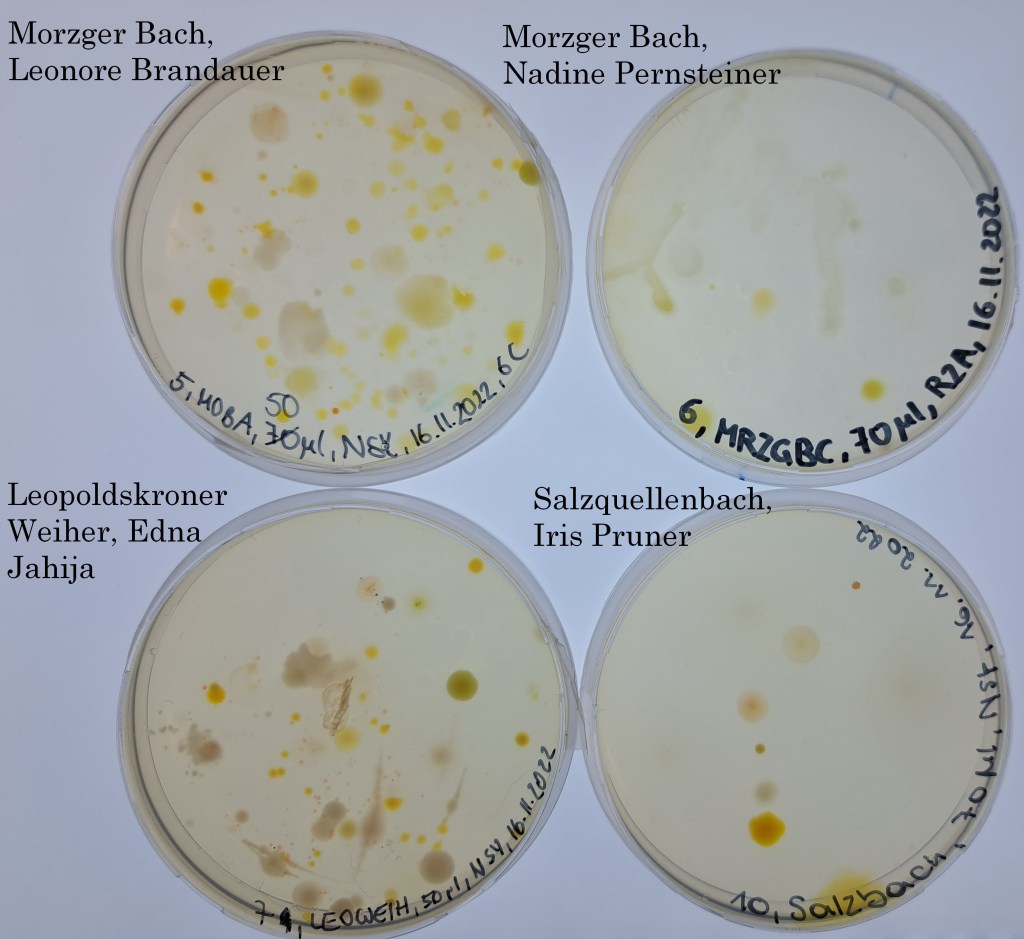
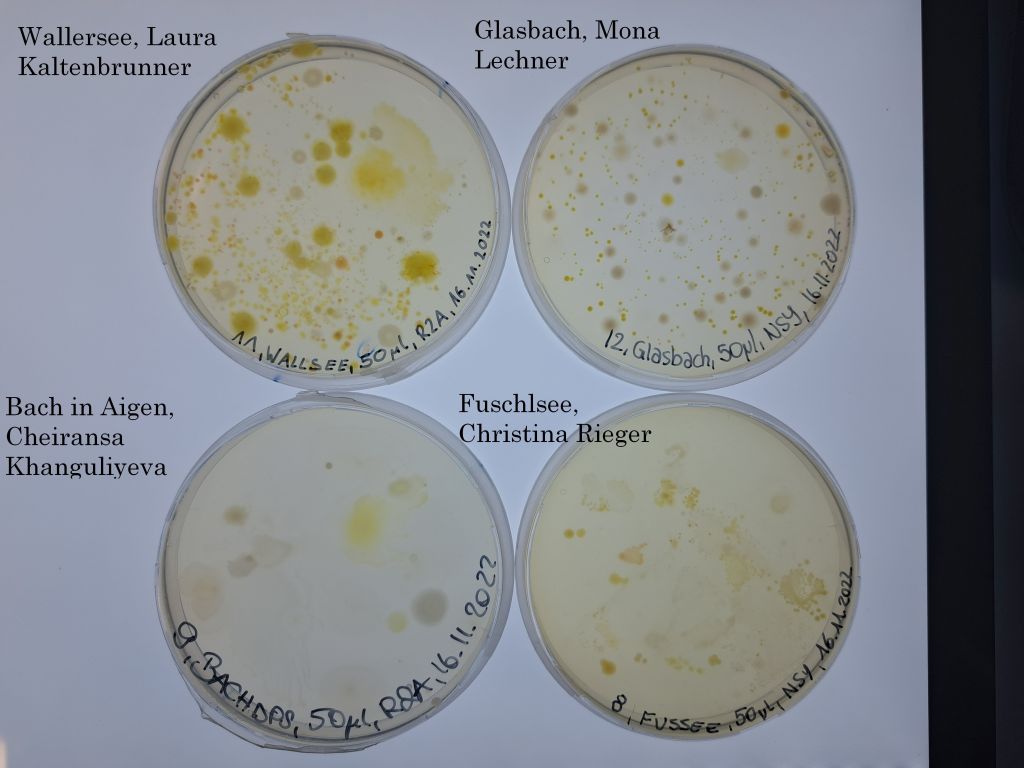
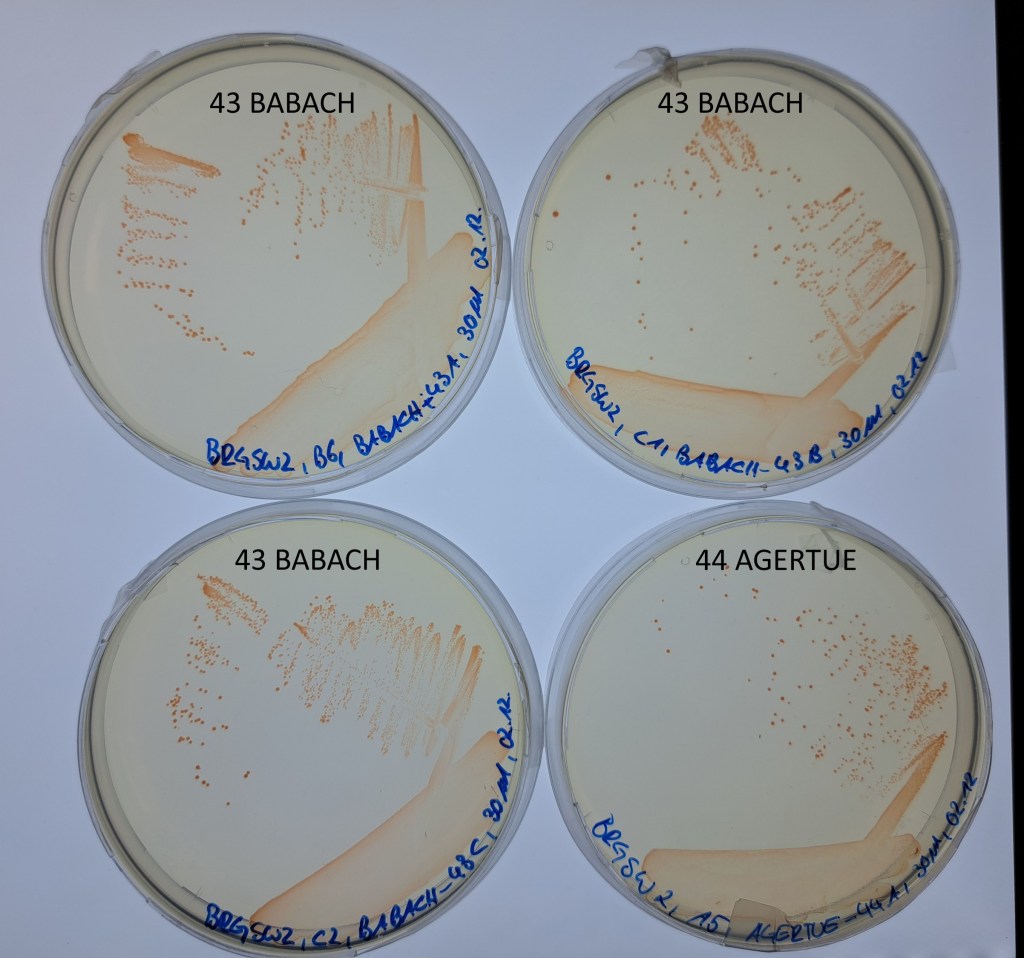
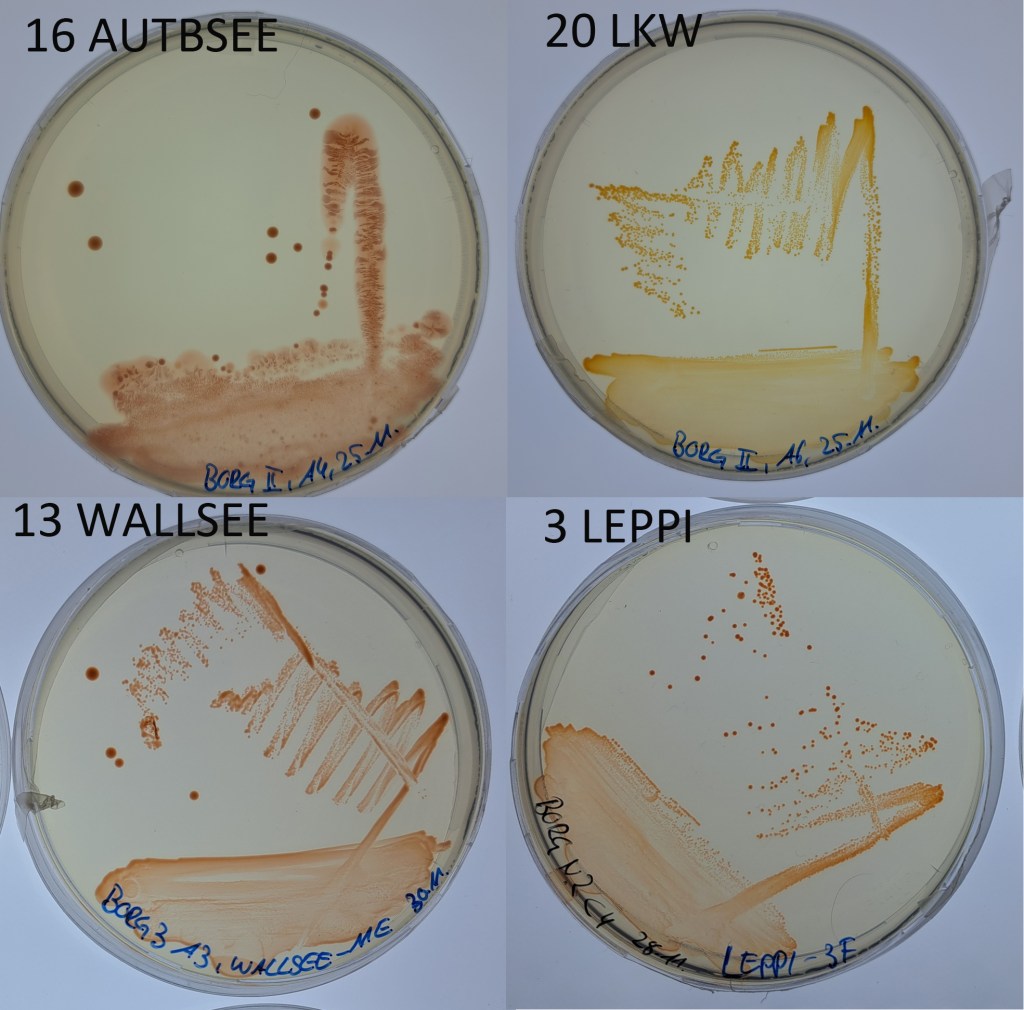
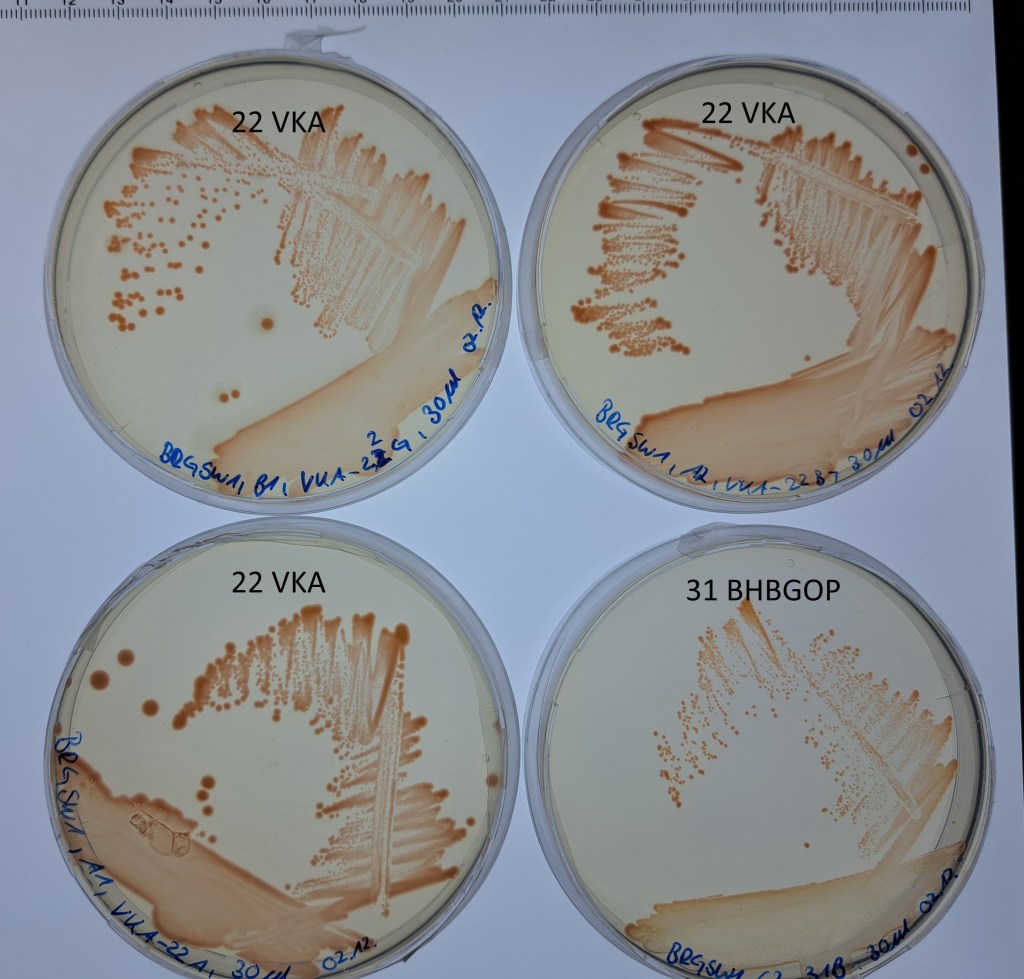
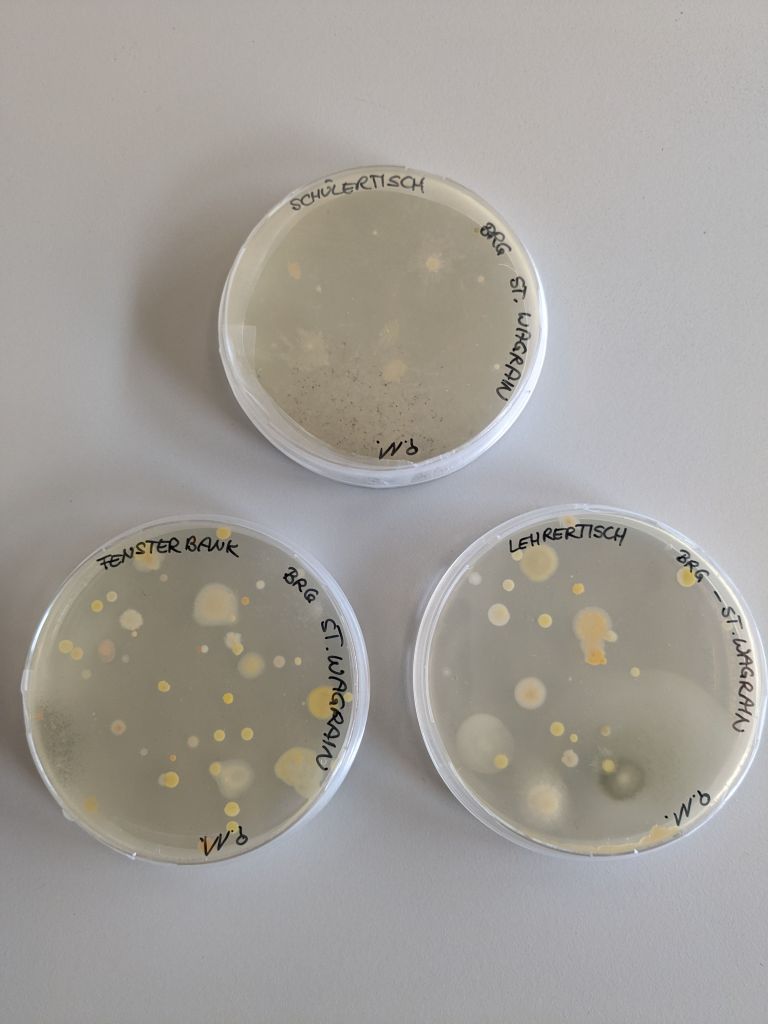
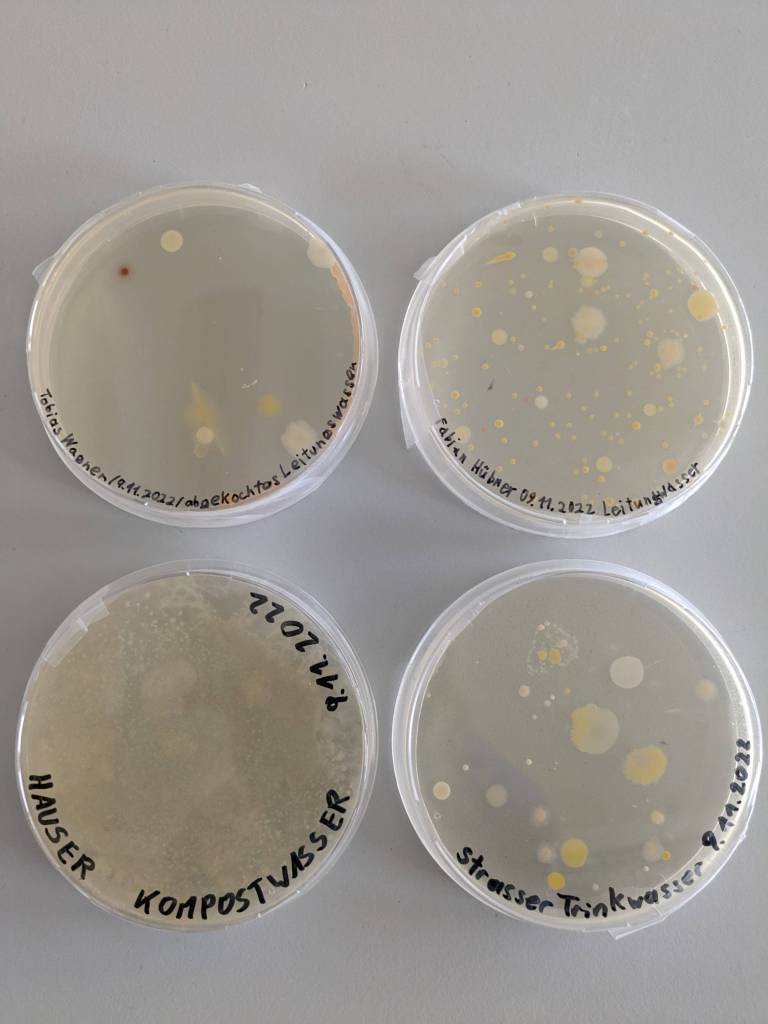
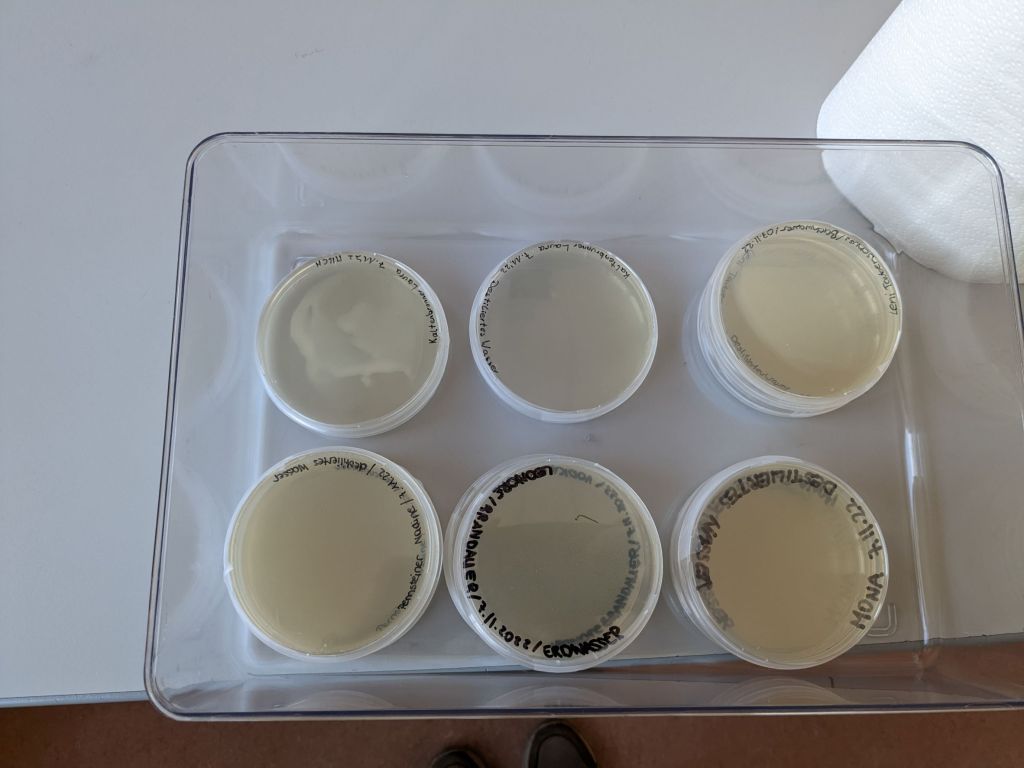

Aquirufa Habitats
The collaboration with the two school classes (BORG Nonntal and BRG Schloss Wagrain) resulted in a lot of bacterial isolates. The cultures grow now on agar plates and in liquid media. With PCR and sequencing of parts of two genes more than 25 strains could be assigned to the target genus Aquirufa. The students and the project team could isolate strains of Aquirufa from 13 water samples of in total 43 samples. This corresponds to 30 % and is a really astonishing portion. It confirmed the impression, that Aquirufa is a widespread group in the surrounding waters. These are the 13: Leopoldskroner Weiher LEOWEIH-7 (Edna Jahija) and LEPPI-3 (Ioanna Polo), WALLSEE-11 (Wallersee, Laura Kaltenbrunner), FUSSEE-8 (Fuschlsee, Christina Rieger), WAEICH-18 (forest pond, Martin Windberger), GLASBACH-12 (Glasbach, Mona Lechner), MRZGBC-6, (Morzger Bach Nadine Pernsteiner), BHBGOP-31 (creek near Gopprechting, Hannah Stockinger), GARBAGER-33 (Ager, Julia Schiller), BABACH-43 (creek at Bach 😉 Martha Wohlschläger), AGERTUE-44 (Ager pond, Ronja Hauser), WATS-35 (a forest pond Schönberg, Kilian Ponget) and DARE-47 (rain water, Sonia Qaiser). From 11 isolates we will sequence the whole genomes to decide which of them represent a new species. They originate from: WALLSEE, LEOWEIH, LEPPI, FUSSEE (if the strain corporates 😉 ), WAEICH, DARE, WATS, BHBGOP, BABACH and GARBAGER.
First results water samples

The students from the two schools BORG Nonntal and BRG Schloss Wagrain had brought water samples from different water habitats and spread them on agar plates. After two weeks of incubation in the lab a lot of bacterial colonies appeared, as you can see on the photos.
In lab we selected the promising colonies with the typical ‚Aquirufa red‘ and brought them into liquid medium. These liquid cultures were spread again on agar plates, some of them can be seen on the pictures:

2. Workshop BRG Schloss Wagrain
At the 23th of November we (Alexandra, Johanna, Stefan) we were guests for a second time at the BRG Schloss Wagrain. We were to early and waited in front of the biology classroom.
First we gave an introduction to the topic of bacteria, what they are and their importance for the environment and for us. The students knew already a lot and contributed their knowledge. Afterwards they worked in two groups, one looked at the agar plates from the first workshop and the others handled the water samples, which they had brought. On the agar plates with drinking water they spot some bacterial colonies. That’s o.k., drinking water contains bacteria, considering the 1,5 kg microorganisms in each human body, it is not so astonishing. On the agar plates with disinfectants and Vodka 😉 no colonies could be detected. We had led also agar plates open in the classroom, on them nicly colored colonies from air bacteria and mold cultures could be seen. Working with the individual water samples was due to the practice of the first workshop quiet easy. We are very curious what will grow on these plates from the students.
1. Workshop BORG Nonntal
At the 7th of Noveber we (Alexandra, Johanna and Stefan) went to our very first workshop of the new project. Our ‚Instagram representative‘ Sabrina joined us. We visited at the school BORG Nonntal the class 6c. At first we gave an introduction to the project. After that the students spread the samples which they brought from at home on agar plates. The task was to bring a liquid sample with and one without bacteria. The work with automatic pipettes and agar plates went really well. The students measured also pH and conductivity in their own one and other samples. Astonishing was, that Vodka has a very low conductivity. We will see, if some microorganisms like the vodka and grow on these plates. The students also received instructions for choosing and sampling a water habitat. We will work with these samples in the next workshop and hope, that we will get a lot of Aquirufa strains and hopefully new species.